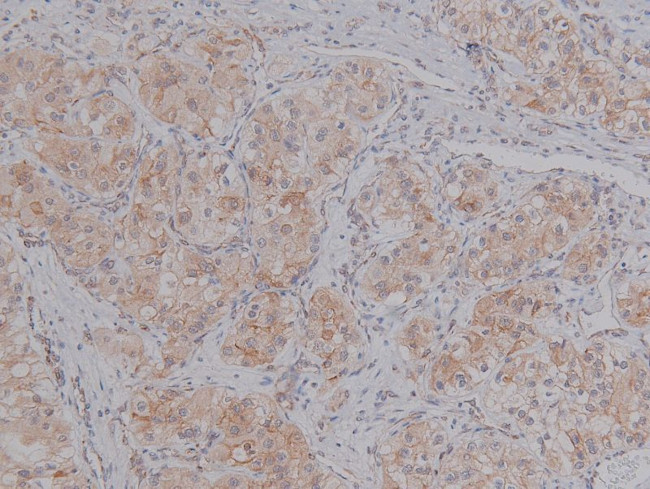
Phospho-BACE1 (Ser498) Antibody in Immunohistochemistry (Paraffin) (IHC (P))

Search
Invitrogen
Phospho-BACE1 (Ser498) Polyclonal Antibody
{{$productOrderCtrl.translations['antibody.pdp.commerceCard.promotion.promotions']}}
{{$productOrderCtrl.translations['antibody.pdp.commerceCard.promotion.viewpromo']}}
{{$productOrderCtrl.translations['antibody.pdp.commerceCard.promotion.promocode']}}: {{promo.promoCode}} {{promo.promoTitle}} {{promo.promoDescription}}. {{$productOrderCtrl.translations['antibody.pdp.commerceCard.promotion.learnmore']}}
图: 1 / 4
Phospho-BACE1 (Ser498) Antibody (PA5-105747) in IHC (P)




Please note: We are reviewing Western blot images included in the antibody testing data in our catalog, including those provided by third parties. Unless expressly labeled or annotated as “raw-unedited”, Western blot images included in the antibody testing data in our catalog may have been edited, optimized or otherwise adjusted for presentation.
产品信息
PA5-105747
种属反应
已发表种属
宿主/亚型
分类
类型
抗原
偶联物
形式
浓度
规格
纯化类型
保存液
内含物
保存条件
运输条件
RRID
产品详细信息
Antibody detects endogenous levels of BACE only when phosphorylated at Ser498.
靶标信息
BACE1 (beta-secretase) is a key enzyme involved in the production of amyloid beta-peptides (Abeta) found in extracellular amyloid plaques of Alzheimer's disease (AD). In some cases early onset familial AD can be attributed to a "Swedish" mutation in the amyloid precursor protein (APP), which dramatically enhances the cleavage of this protein by BACE1. This and other genetic and pathological evidence has led to therapeutic approaches that have focused on the inhibition of BACE1 and other APP-cleaving enzymes, such as gamma-secretase stuff. APP is first cleaved by b-secretase, producing a soluble derivative of the protein and a membrane anchored 99-amino acid carboxy-terminal fragment (C99). The C99 fragment serves as substrate for g-secretase to generate the 4 kDa amyloid-b peptide, which is deposited in the brains of all sufferers of Alzheimer's disease. The long-sought b-secretase was recently identified by several groups independently and designated beta-site APP cleaving enzyme (BACE) and aspartyl protease 2 (Asp2). bACE/Asp2 is a novel transmembrane aspartic protease and colocalizes with APP.
仅用于科研。不用于诊断过程。未经明确授权不得转售。
生物信息学
蛋白别名: APP beta-secretase; asp 2; ASP2; Aspartyl protease 2; BACE 1; BACE-1D; BACE-I-432; Beta secretase; Beta-secretase 1; Beta-site amyloid precursor protein cleaving enzyme 1; Beta-site APP cleaving enzyme 1; Memapsin; Memapsin-2; Memapsin2; Membrane-associated aspartic protease 2
基因别名: BACE; BACE1; C76936; KIAA1149
UniProt ID: (Rat) P56819, (Mouse) P56818
Entrez Gene ID: (Rat) 29392, (Mouse) 23821